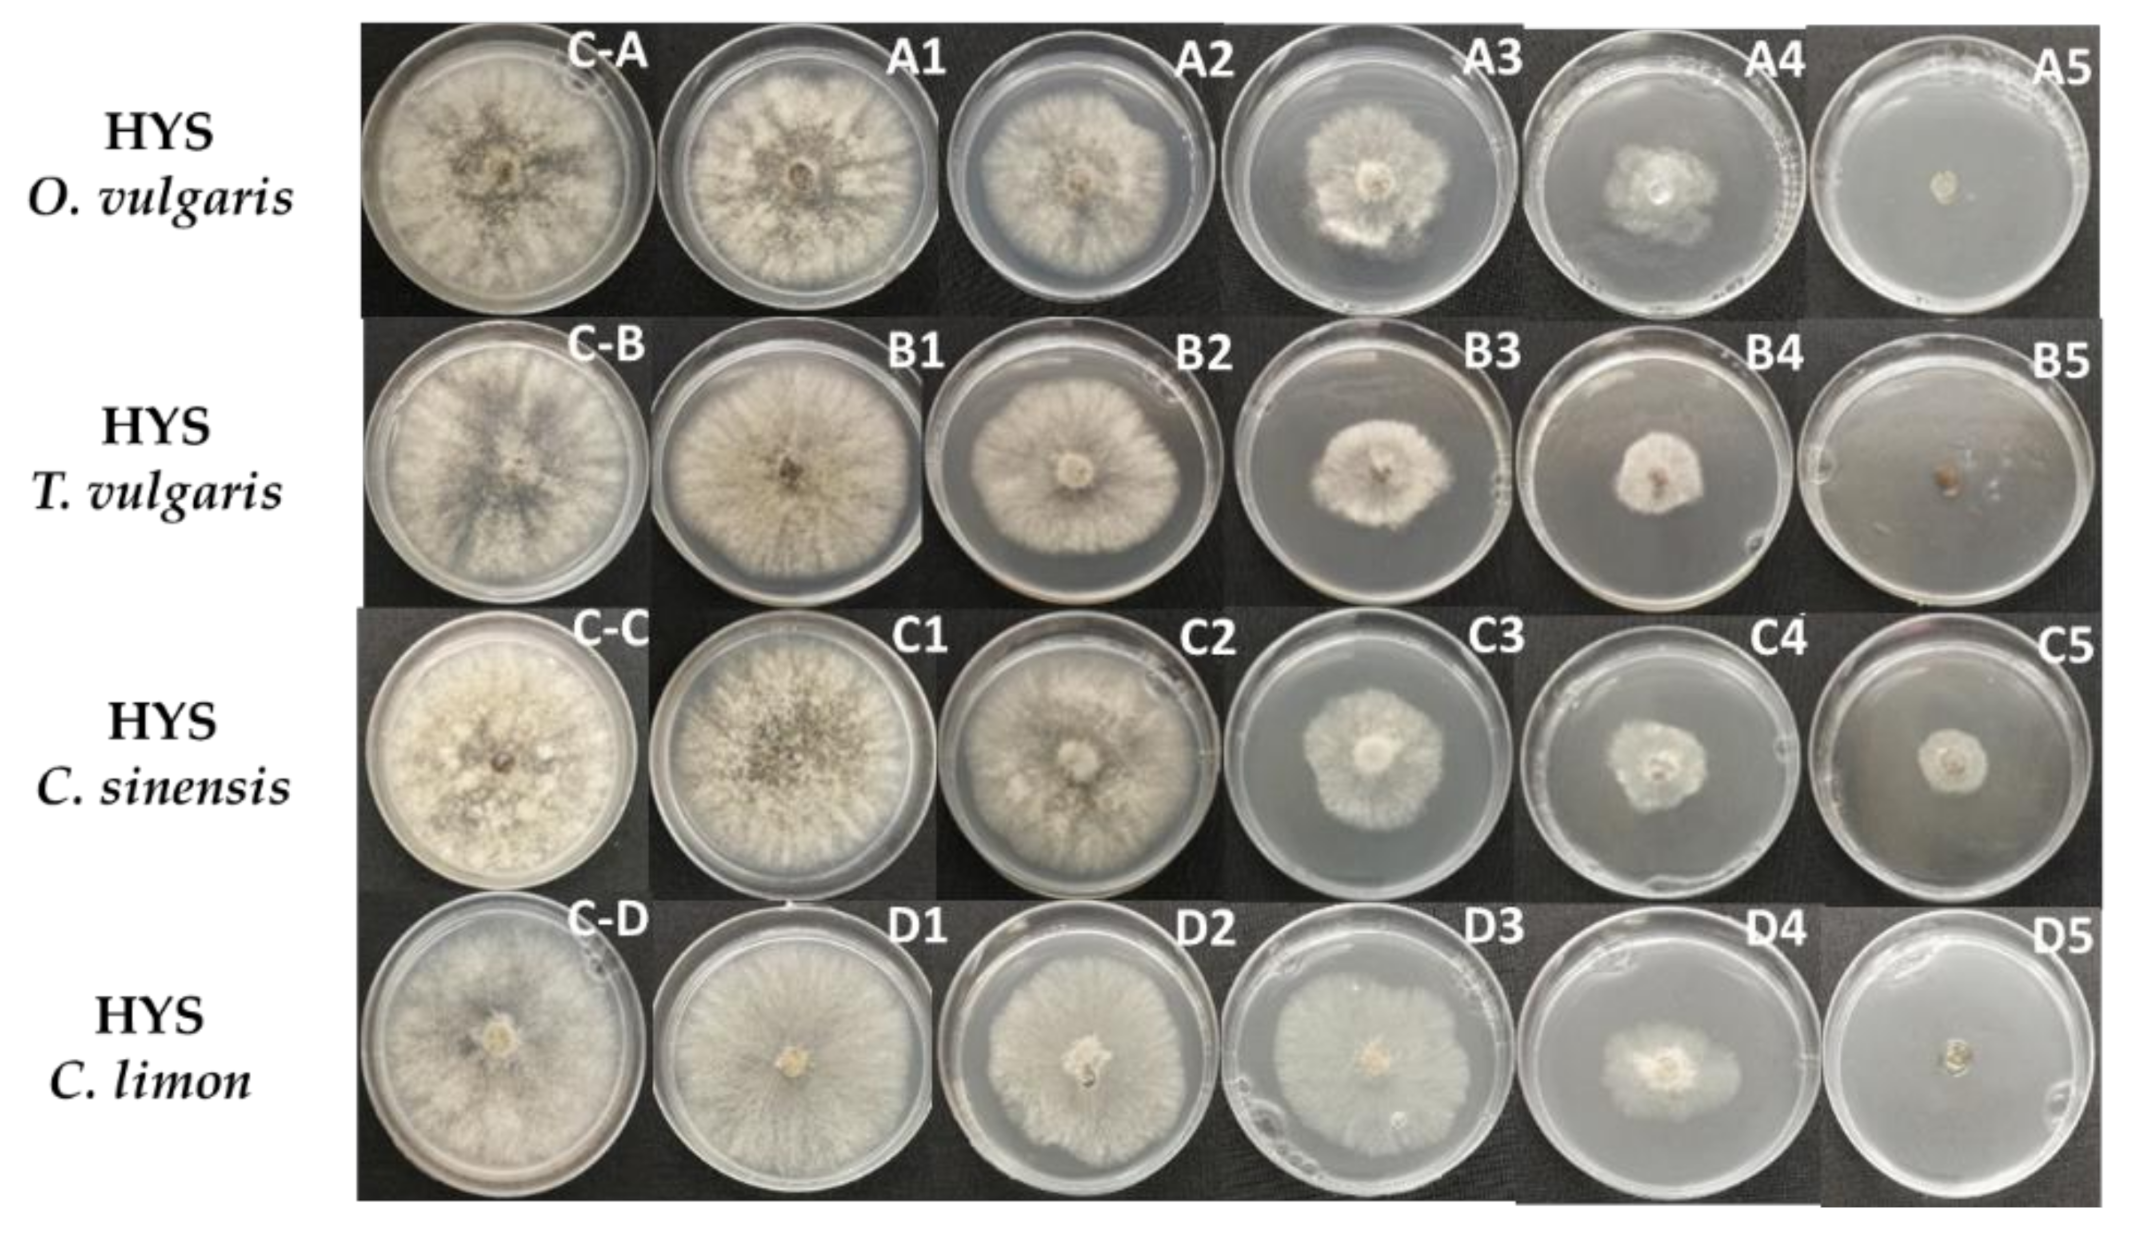
Plants 10 01719 g002

Abstract
Gray mold disease, which is caused by Botrytis cinerea Pers ex. Fr., results in serious economic losses to Lycopersicum esculentum (tomato) crop productivity. In this study, we explored the possibility that mixtures of essential oils (EOs) and their respective hydrolates (HYSs) could be used to control this disease. Thus, EOs and HYSs were obtained from Origanum vulgare, Thymus vulgaris, Citrus limon, and Citrus sinensis by hydrodistillation. In vitro antifungal activities were evaluated, and EC50 values of 15.9 and 19.8 µg/mL were obtained for EOs of thyme and oregano, respectively. These activities are due mainly to volatile compounds, thymol and carvacrol. Results from in vivo assays show that although most tomatoes were infested five days after inoculation, the damage was considerably reduced by the application of an EO/HYS mixture of thyme. The disease incidence indexes of B. cinerea tomato rot, percentage and severity, measured four days after inoculation, were reduced by 70% and 76%, respectively, as compared with the inoculum control. These results suggest that a combination of HYSs and EOs enhances antifungal activity, and that optimization of relative concentrations, volumes, and the nature of the compounds, could design a formulation able to control B. cinerea inoculum on tomato fruits.
1. Introduction
Botrytis cinerea is a phytopathogenic fungi, also known as “gray mold fungus”, that causes serious pre- and postharvest diseases in more than 200 different plant species, but considering other Botrytis spp., this number increases to 1500, including important food crops [1,2]. The gray mold disease affects almost every aspect of attacked plants during growth, storage, and transport of the final product. Therefore, the ubiquitous presence of B. cinerea results in significant economic losses to the horticulture and fruit industry, and it has been estimated that at least 20% of world crops are affected by B. cinerea, producing economic losses of approximately 10–100 million USD per year. Crop protection agents (CPAs), currently used to control B. cinerea, are mainly synthetic chemical compounds designed to prevent infection and to minimize postharvest losses [3]. Although these CPAs present a variety of modes of action against B. cinerea, the magnitude and frequency of fungicidal treatments have induced the appearance of resistant isolates of this fungus [4]. Thus, the economic importance of infected crops and appearance of resistant isolates has prompted the quest of new and efficient antifungal CPA. However, the negative public perception related to application of chemicals that could contaminate ground and natural water sources, has led this research to assess natural products with antifungal properties. In this approach, numerous plants have been studied and plant metabolites with various antibiotic, anticancer, and antifungal activities have been extracted, isolated, and characterized [5,6,7,8,9,10]. Then, the most active compounds have been chemically modified to obtain analogs to enhance their activities [11,12,13]. Different series of synthetic analogs have been evaluated against B. cinerea and results have been used to establish structure-activity relationships [14,15,16]. In addition, it has been known for many centuries that aromatic plants are a source of compounds possessing interesting properties for different applications. Complex mixtures of volatile compounds such as terpenes and terpenoids, generically known as essential oils (EOs), are obtained by extraction of aromatic plants, and so far, more than 3000 EOs have been identified and at least 300 have enormous economic importance due to their increased use in food, pharmaceutical, cosmetic, and perfume industries [17,18]. EOs are commonly obtained by steam distillation or hydrodistillation, and at the end of this process, hydrosols or hydrolates (HYSs) are obtained as an aqueous fraction that separates from the EOs [19]. GC-MS analysis and/or NMR spectroscopy have demonstrated that nonpolar molecules are the main components of EOs, whereas more hydrophilic molecules and traces of EOs form HYSs [20]. Thus, the physicochemical, and biological properties of both EOs and HYSs depend on the nature and relative concentration of their compounds [21,22]. Several studies have shown that EOs and HYSs exhibit biological activities, such as, cytotoxicity, antioxidant, antibacterial, and antifungal [23,24,25,26,27,28,29,30], which depend on the nature and relative concentration of their compounds. Interestingly, the activity of EOs seems to be higher than that of separate compounds, indicating the existence of a synergic effect [31,32,33]. Thus, much effort has been dedicated to enhancing these activities either by combining different EOs or adding some active compounds [34,35,36,37]. In the present study, antifungal activities of EOs and HYSs obtained from oregano (O. vulgare), thyme (T. vulgaris), lemon (Citrus limon), and orange (Citrus sinensis), against Botrytis cinerea have been investigated assessing their effects on hyphal growth. In addition, preventive effects of EOs, HYSs, and their mixtures were also studied by evaluating in vivo the development of gray mold disease affecting tomato fruits. We have focused our attention on tomato (Lycopersicum esculentum) because it is one of the most important Solanaceous crops and gray mold affects leaves and fruits, and even during postharvest, B. cinerea induces severe fruit rot [38,39,40].
2. Results and Discussion
Essential oils are commonly obtained by different methods such as, hydrodistillation, solvent extraction, and supercritical fluids extraction [19]. In this study, steam distillation, which is the most widely used method due to its low cost [41], was used to obtain EOs and HYSs from T. vulgaris, O. vulgare, C. sinensis, and C. limon. The yields of EOs were in the range of 0.50–1.75% mL/in a 100 g of dry vegetal material basis.
2.1. In Vitro Antifungal Activity of EOs and HYSs
The antifungal activities of EOs and HYSs were evaluated by measuring mycelial growth inhibition of B. cinerea. Radial growth of B. cinerea mycelium in potato dextrose agar (PDA) in the absence and presence of different concentrations (%v/v) of EOs and HYSs, obtained from O. vulgare, T. vulgaris, C. sinensis, and C. limon, are shown in Figure 1 and Figure 2, respectively.
Figure 1.
Effect of EOs, obtained from O. vulgare, T. vulgaris, C. sinensis, and C. limon, on mycelial growth of B. cinerea in PDA. EOs and positive control (BC-1000® Dust) were applied at different concentrations (%v/v): (C-A–C-E) (negative control), 0.0; (A1–E1) 9 × 10−4; (A2–E2) 9 × 10−3; (A3–E3) 2.2 × 10−2; (A4–E4) 4.5 × 10−2; (A5–E5) 11 × 10−2.
Figure 2.
Effect of HYSs, obtained from O. vulgare, T. vulgaris, C. sinensis, and C. limon, on mycelial growth of B. cinerea in PDA. HYSs were added in aqueous solution at different concentrations (%v/v): (C-A–C-E) (negative control), 0.0; (A1–D1) 0.02; (A2–D2) 0.2; (A3–D3) 1.0; (A4–D4) 10; (A5–D5) 25.
The values of growth inhibition percentage induced by EOs and HYSs for all studied essential oils are given in Table 1 and Table 2, respectively.
Table 1.
Percentage of inhibition of B. cinerea mycelial growth induced by different concentrations (%v/v) of T. vulgaris, O. vulgare, C. sinensis, and C. limon EOs, three days after incubation.
Table 2.
Percentage of inhibition of B. cinerea mycelial growth induced by HYSs of T. vulgaris, O. vulgare, C. sinensis, and C. limon at different concentrations (%v/v) three days after incubation.
The results obtained from the inhibition test in PDA show that the effects of both EOs and HYSs are dose dependent. In addition, the data listed in Table 1 and Table 2 indicate that EOs of O. vulgare and T. vulgaris are the most active for controlling B. cinerea growth. The fungus growth is completely inhibited at concentrations from 4.5 × 10−2 to 6.7 × 10−2%v/v (from 400 to 600 ppm). Similar results have been previously reported for T. vulgaris [42] and other species of oregano and thyme, i.e., T. glandulosus and O. compactum [43], and T. capitatus [44]. This inhibitory effect has been attributed to the presence of thymol and/or carvacrol [25]. These two phenolic isomer compounds are major constituents of thyme and potential application of this EO in the food industry due to its antioxidant and antimicrobial properties conferred by carvacrol and thymol have been recently reviewed [45].
To quantify the growth inhibition effect, the concentration needed to inhibit 50% of the pathogen was determined, namely the EC50 value. The EC50 values were obtained by fitting the measured percentage of inhibition to a dose-response function, and therefore they better represent the variation of inhibition with the dose of active compound. The EC50 values for growth inhibition of B. cinerea by EOs and HYSs are given in Table 3.
Table 3.
EC50 values calculated for inhibition of mycelial growth of B. cinerea in vitro. Measurements were performed three days after incubation.
The data in Table 3 indicate that T. vulgaris and O. vulgare EOs are the most efficient inhibitors of mycelial growth in this study, with EC50 values of 15.9 and 19.8 ppm, respectively. These values are very similar to those determined for thymol and carvacrol [43]. Considering these results, and even though all studied EOs have been previously described, we determined the compositions of these two EOs (Table 4). It is worth mentioning that thymol and carvacrol were found in T. vulgaris EO, whereas only thymol was detected in O. vulgare EO. This result suggests that most of the antifungal activity observed for these EOs is due to these two isomers.
Table 4.
Chemical composition of essential oils extracted from leaves of T. vulgaris (thyme) and O. vulgare (oregano) determined by gas chromatography coupled to mass detection (GC-MS).
In addition, in vitro inhibition of hyphal growth of B. cinerea by HYSs has also been assessed. It is well known that, unlike essential oils, hydrolates are water-miscible phases in which a complex mixture of oxygenated compounds, such as alcohols, ketones, ethers, aldehydes, and esters, and very low percentages of terpenes are dissolved [46]. Therefore, HYS-induced inhibition is due to low concentrations of active compounds having enhanced diffusion in the aqueous medium. The data obtained for HYSs (Table 2 and Table 3) indicate that HYS C. sinensis is the most active, and its EC50 value is 3 to 10 times lower than that measured for the HYSs of the other EOs. This result suggests that polar compounds of C. sinensis are more active or are in higher concentrations than in the other studied EOs. A comparison of EO and HYS activities, measured by the EC50 values, show that EO activities are much higher than those observed for the respective HYSs, namely the EC50(HYS)/EC50(EO) ratio is approximately 13 for O. vulgare and T. vulgaris, 4 for C. limon, and 1 for C. sinensis. These results confirm that the main activity of O. vulgare and T. vulgaris EOs against B. cinerea is due mainly to nonpolar volatile compounds, whose concentrations are higher in the EO phase than in the polar HYSs. However, this difference is almost nil for C. sinensis suggesting that in this HYS there are polar compounds with significant activity against B. cinerea, and in addition, the amount of active volatile compounds in this EO is much lower than in O. vulgare and T. vulgaris EOs.
2.2. Chemical Composition of Essential Oils of T. vulgaris and O. vulgare
The chemical composition of EOs was determined by GC-MS (Figures S1 and S2, Supplementary Materials) and the results are in line with previous reports [42,47,48,49]. The major compounds of T. vulgaris EO were thymol (56.62%), p-cymene (17.52%), and carvacrol (5.11%), whereas O. vulgare EO contains mainly γ-terpinene (32.48%), α-terpineol (18.35%), terpinen-4-ol (19.01%), and thymol (5.45%). The assignments of chemical structure, presented in the chromatograms (Figures S1 and S2) and in Table 4, were obtained by comparing the mass spectra of each peak with those of the NIST11.lib database, provided by the software equipment. Additionally, the values obtained for the detected ions (m/z) were compared with reference data (Table S1) [50].
2.3. In Vivo Assays of Antifungal Activities of EO/HYS Mixtures and HYSs
In vivo activities of the most active EO and HYS compounds were assessed using ripe and healthy tomato fruits, which were previously sterilized and wounded. EO/HYS mixtures and HYSs of T. vulgaris and O. vulgare were sprayed on the wounds, and then a conidial suspension of B. cinerea was applied to inoculate the wounded fruits. Daily photographs of fruits submitted to different treatments are shown in Figure 3.
Figure 3.
Effects of mixtures of (EO/HYS) and hydrolates (HYSs) of T. vulgaris and O. vulgare at different concentrations for controlling gray mold caused by B. cinerea on tomato fruits for five days post inoculation (dpi): (A) Control (-); (B) inoculum Control; (C) EO/HYS 0.135/30 (%v/v), thyme; (D) HYS 30%v/v, thyme; (E) EO/HYS 0.135/30 (%v/v), oregano; (F) HYS 30%v/v, oregano; (G) BC-1000® 0.135%v/v.
A visual inspection of results shown in Figure 3 indicate that, in the negative control, the first symptoms of gray mold disease appear two days after inoculation, whereas with EO/HYS mixtures and HYSs from thyme and oregano, the fungal infection is noticed 4 and 5 days after infection, respectively. A comparison of treatments with EO/HYS mixtures (rows C and E) and HYSs (rows D and F) indicates that thyme (rows C and D) is slightly more active than oregano (rows E and F), and definitely more effective than BC-1000®, the organic fungicide control.
To quantify these effects, the disease incidence percentages (DIP) were calculated [51], and the results obtained over five days after inoculation are given in Table 5.
Table 5.
Effect of different treatments applied in vivo on tomato fruits on the incidence of Botrytis cinerea disease over five days post-inoculation (dpi).
The results obtained for the inoculum control show that B. cinerea infects tomato wounds very quickly, i.e., 10% at Day 1, 50% at Day 2, and 100% at Day 3 after inoculation. Treatment with the HYS/EO thyme mixture reduces these numbers to 0%, 10%, 30%, and 60% from 1 to 4 dpi, respectively. On Day 5 after inoculation, all tomato fruits become infected. Interestingly, applications of HYSs and the EO/HYS mixtures produce similar protecting effects, even though the in vitro EO growth inhibition effect concentration of the most active compounds is lowest in HYSs. It is possible that the application method determines the efficiency of adsorption of volatile compounds on the fruit surface, and consequently their antifungal activity. This result suggests that the germination process of spores inoculated on tomato surface is reduced, but hyphal growth is not affected by the presence of active compounds from EOs and/or HYSs.
The disease severity index (DSI) was evaluated using a visual scale and calculated with the Townsend–Heuberger equation [52]. The results are presented in Figure 4 as the percentage of damaged fruits for each dpi. Interestingly, the highest value of DSI (50%) was reached four days after inoculation by the inoculum control, and all assayed treatments show a reduction on this index. The highest decrease in DSI is obtained for fruit treated with the EO/HYS mixture obtained from thyme.
Figure 4.
Disease severity index (%DSI) on tomato fruits measured for five days post inoculation (dpi). Values are expressed as mean ± SD. Means with the same letter are not significantly different at p ≤ 0.05 using the LSD test.
In summary, thyme EOs and HYSs exhibit the highest antifungal activities against B. cinerea inoculated on tomato fruit. The lowest values of both DIP and DSI were obtained for the EO/HYS thyme mixture at concentrations 13.5 × 10−2/30 (%v/v). It is worthwhile to emphasize that HYSs account for a significant part of these effects. For example, this EO/HYS mixture induces a reduction of 70% and 76% in DPI and DSI, measured four days after inoculation, whereas HYSs alone reduce these indexes by 25% and 30%, respectively, as compared with the inoculum control. Similar results are found for HYSs and the EO/HYS mixture from oregano, even though the magnitude of the index reduction is lower than that determined for thyme.
3. Materials and Methods
3.1. Plant Material
Origanum vulgare and Thymus vulgaris used in this study are herbaceous plants belonging to the Lamiaceae family. Oregano plants were collected at the flowering state, in 2019, from Olmué, Valparaíso, Chile. Thyme plants were collected at the vegetative state, in March 2019, from El Manzano, San José de Maipo, XIII region, Chile. The foliage materials of both plants were dried at room temperature (23 °C) before the extraction process. The fruits of Citrus limon and Citrus sinensis of the Rutaceae family were collected, in September 2019, from plants cultivated at Olmué, Valparaíso, Chile.
3.2. Extraction of Essential Oils (EOs) and Hydrolates (HYSs)
All essential oils were obtained through the steam distillation method. Dry leaves of T. vulgaris, C. limon, and C. sinensis (400 g) were crushed and placed in a 2 L distillation flask designed by LABSUN. The plant material was covered with 1.3 L of distilled water, and the distillation process was maintained for 2 h. Finally, the essential oils were separated from the hydrolates by means of a burette. In the case of O. vulgare, the leaves (450 g) were placed in the slit of the distillation tower and submitted to stream distillation for 3 h. The essential oils and hydrolates were separated through a burette. Both essential oils and hydrolates were stored separately in amber bottles at 4 °C.
3.3. Fungal Material
The B. cinerea isolate was obtained from infested orchard vine grapes, and grown on dextrose potato agar (PDA) for 1 week at 23 °C. The pure culture was stored in the pathogen collection of the Biological Testing Laboratory of the Chemistry Department of Universidad Técnica Federico Santa María. Conidial suspension of 1 × 106 conidia/mL was obtained by scraping a 10-day culture in sterile 0.05% Tween 20 aqueous solution using a hematocytometer.
3.4. Preparation of Essential Oil (EO) and Hydrolate (HYS) Solutions
Essential oil (200 µg) was mixed with water and Tween 20, to obtain the EO stock solution of 0.45%v/v (4000 ppm), whereas hydrolates were mixed with water and Tween 20, to obtain the HYS stock solution of 30%v/v.
The EO/HYS mixtures were prepared by mixing essential oil (200 µg) with HYS stock solution to obtain EO/HYS 0.45/30%v/v.
3.5. In Vitro Mycelial Growth Inhibition of Essential Oils and Hydrosols
Agar Dilution Method
Antifungal activity was determined using the agar dilution method, according to the method previously described [15]. The solutions were used, as previously described, to obtain different concentrations of EOs (0.009 × 10−2–11 × 10−2%v/v) and HYSs (0.02–25%v/v). The same concentrations of the positive control BC-1000® Dust, CHEMIE (commercial organic fungicide), were used. The tests were carried out in 50 mm diameter petri dishes adding PDA mixed with EO, HYS, and BC-1000® Dust at the concentrations and volumes indicated. The fungus was seeded by placing a 4 mm diameter inoculum disk in the center of each petri dish and allowed to incubate for 3 days at 23 °C. A negative control was performed only with the PDA culture medium. Three replicates were made for each treatment. After 3 days, the growth halo of the pathogen was measured to calculate the percentage of mycelial inhibition (%I) as compared with the control. Additionally, the effective concentration that inhibited the growth of the mycelium by 50% (EC50) was obtained by adjusting %I and the concentration to a dose-response equation. The fit analysis was performed using OriginPro 8.0 software (Origin Lab Corporation, Northampton, MA, USA).
3.6. In Vivo Antifungal Activity of HYSs and Mixtures of EO/HYS In Vivo against Gray Mold on Tomato Fruits
Tomato fruits were obtained from a commercial market, washed with plenty of running water and superficially sterilized with a 15% sodium hypochlorite solution. Then, they were rinsed with distilled water and dried with sterile absorbent paper towel. After drying, they were placed in sterile plastic boxes, and four wounds per tomato were made using a sterile syringe. HYSs (15%v/v and 30%v/v) and EO/HYS mixtures (0.067/15%v/v and 0.135/30%v/v) were applied by spraying and, immediately thereafter, tomatoes were inoculated by spraying 1 mL of spore suspension (1 × 106 conidia/mL) on the wounds of each fruit. Each experiment consisted of three replicates and each replica had four tomatoes. Organic fungicide BC1000® Dust was used as a positive control at the same EO concentrations. Two additional sets of fruit were prepared, in one of them only water was added, and in the other, inoculum was added. All fruits were stored at 25 °C and 95% relative humidity for 5 days. At the end of storage, the disease incidence percentage (DIP) was calculated as DIP = (number of infected lesions)/(number of assessed lesions) × 100 [51]. The disease severity index (DSI) was calculated through the Townsend-Heuberger equation [52,53]. This equation uses a visual scale of symptoms: (1), no visible symptoms (not infected); (2), 1–25% of the inoculated area is covered with a slight necrotic mycelia (mild infection); (3), 26–50% of the inoculated area is covered with necrotic mycelia (moderate infection); (4), 51–75% of sample are necrotic with appeared spore masses (strong infection); (5), 76–100% of the necrotic tissue appears soft and decays with a fungal mass (very severe infection) (Figure 5).
Figure 5.
Visual scale (1–5) of symptoms caused by B. cinerea to quantify the incidence and severity of the disease on tomatoes: (A) 1 = There are no visible symptoms (not infected); (B) 2 = 1–25% of the inoculated area is covered with a slight necrotic mycelium (mild Infection); (C) 3 = 26–50% of the inoculated area is covered with necrotic mycelia (moderate Infection); (D) 4 = 51–75% of sample are necrotic with appeared spore masses (strong Infection); (E) 5 = 76–100% of the necrotic tissue appears soft and decays with a fungal mass (very Severe Infection).
A nonparametric analysis of the DIS data, obtained during the five days of post-inoculation treatment, was performed with the Matlab program 2020a, (Mathworks Inc., Natick, MA, USA) and using the multi-comparison function with a least significance difference test (LSD) with a p ≤ 0.05 of significance.
The confirmation of infection by B. cinerea was carried out by isolating the pathogen from tomato lesions and the morphological characteristics of the colony and conidia were identified under the Leica EZ4HD Stereo Microscope with camera software and DM500 microscope (Leica Microsystems, Wetzlar, Germany).
3.7. Chromatographic Analyses of O. vulgare and T. vulgaris
The chromatographic analyses of essential oils obtained from of O. vulgare and T. vulgaris were carried out in a GCMS-QP2010 (SHIMADZU Gas Chromatograph-Mass Spectrometer, Japan), equipped with a capillary column Rtx-5MS (30 m, 0.25 mm internal diameter, 0.25 µm film thickness) and a 5971 A mass spectrometer detector. Helium was used as carrier gas, at a flow rate of 1.61 mL/min. The column temperature was initially set to 60 °C for 5 min, and gradually increased to 160 °C (5 °C/min), and finally increased to 280 °C (15 °C/min). The injector and detector temperatures were set at 250 and 280 °C, respectively. For detection by GC-MS, an electron ionization system with an ionization energy of 70 eV was used. EOs were diluted with dichloromethane (1:1000 v/v), and 1.0 µL of diluted samples were automatically injected into no division mode. The results were obtained by comparing the mass spectra of each peak with the NIST11.lib database provided by the instrument’s software. Identification was given to those peaks exceeding the 93–95% coincidence. Additionally, calibration curves of standard compounds (Thymol) were performed and used for quantification.
4. Conclusions
Formulations based on EOs and HYSs exhibit antifungal activity against B. cinerea, both in vitro and in vivo. In all the experiments, the assayed treatments were more effective than BC-1000® Dust, which is a nontoxic fungicide based on grapefruit (Citrus × paridisi) seed and pulp extracts. The antimicrobial activity is due to one or more compounds present in the EOs and HYSs. Thus, in vitro inhibition of EOs is attributed mainly to the activity of volatile compounds, whereas the HYS activity is due to polar compounds that are not present in the respective EOs. The latter are especially important in C. sinensis, where the lowest EC50 value was obtained for HYSs, several times lower than that measured for C. limon.
Assessments of the in vivo preventive effects against B. cinerea were carried out using tomato fruit and EO/HYS formulations. DIP and DIS were determined five days after inoculation and the results indicate that preventive effects depend on relative concentration and nature of both EOs and HYSs. Although most tomatoes were infested at 5 dpi, the damage was considerably reduced by application of the EO/HYS mixtures. These results suggest that a combination of HYSs and EOs enhances antifungal activity, and that by varying concentrations, volumes, and the nature of the compounds it would be possible to reach a lower level of incidence and damage and could be possible to achieve complete control of B. cinerea inoculum on tomato fruits.
Thus, mixtures of EOs/HYSs could be developed as a potential formulation for in vivo application in agricultural disease control. It is important to emphasize that the final formulation would be completely natural, minimizing the negative environmental impact caused by synthetic fungicides, and at the same time, would not represent a risk to human health. In addition, being a product that uses HYSs as an active compound, it contributes to the development of the circular economy, giving added value to a by-product that is generally discarded.
Antifungal activities of mixtures of EOs and HYSs from different sources are currently being evaluated.
Supplementary Materials
The following are available online at https://www.mdpi.com/article/10.3390/plants10081719/s1, Figure S1: Chromatogram GC-MS of essential oil obtained from Thymus vulgaris, and chemical structures of identified compounds, Figure S2: Chromatogram GC-MS of essential oil obtained from Oreganum vulgare (oregano), and chemical structures of identified compounds, Table S1: Retention times and quantification ions of compounds present in essential oils extracted from leaves of T. vulgaris (thyme) and O. vulgare (oregano) using gas chromatography coupled to mass detection (GC-MS).
Author Contributions
C.B., methodology, formal analysis, investigation; writing—review; L.E., formal analysis, writing—review; H.H., review and editing; M.F., formal analysis, software, investigation; A.F.O., formal analysis, writing—review and editing; S.P., conceptualization, resources, supervision, investigation; K.D., conceptualization, supervision, methodology, investigation, formal analysis, writing—review and editing. All authors have read and agreed to the published version of the manuscript.
Funding
This research was funded by the Biological Testing Laboratory, Chemistry Department, Universidad Técnica Federico Santa María; and Empresa LabSun, Valparaíso, Chile.
Institutional Review Board Statement
Not applicable.
Informed Consent Statement
Not applicable.
Data Availability Statement
Not applicable.
Acknowledgments
Authors acknowledge to “Dirección General de Investigación, Innovación y Emprendimiento of Universidad Técnica Federico Santa María (DGIIE-UTFSM)”.
Conflicts of Interest
The authors declare no conflict of interest.
References
- Jarvis, W. Botryotinia and Botrytis Species: Taxonomy, Physiology and Pathogenicity—A Guide to the Literature; Research Branch, Canada Department of Agriculture: Ottawa, ON, Canada, 1977. [Google Scholar]
- Elad, Y.; Pertot, I.; Prado, A.M.C.; Stewart, A. Plant Hosts of Botrytis spp. In Botrytis—The Fungus, the Pathogen and Its Management in Agricultural Systems; Fillinger, S., Elad, Y., Eds.; Springer International Publishing: Cham, Switzerland, 2016; p. 413. [Google Scholar]
- Fillinger, S.; Walker, A.S. Chemical Control and Resistance Management of Botrytis Diseases. In Botrytis—The Fungus, the Pathogen and Its Management in Agricultural Systems; Fillinger, S., Elad, Y., Eds.; Springer International Publishing: Cham, Switzerland, 2016; p. 189. [Google Scholar]
- Leroux, P. Chemical control of Botrytis and its resistance to chemical fungicides. In Botrytis: Biology, Pathology and Control; Elad, Y., Williamson, B., Tudzynski, P., Delen, N., Eds.; Kluwer Academic Press: Dordrecht, The Netherlands, 2004; pp. 195–222. [Google Scholar]
- Cragg, G.M.; Newman, D.J. Natural products: A continuing source of novel drug leads. Biochim. Biophys. Acta Gen. Subj. 2013, 1830, 3670–3695. [Google Scholar] [CrossRef] [PubMed] [Green Version]
- Cragg, G.M.; Grothaus, P.G.; Newman, D.J. Impact of Natural Products on Developing New Anti-Cancer Agents. Chem. Rev. 2009, 109, 3012–3043. [Google Scholar] [CrossRef]
- Grayer, R.J.; Kokubun, T. Plant-fungal interactions: The search for phytoalexins and other antifungal compounds from higher plants. Phytochemistry 2001, 56, 253–263. [Google Scholar] [CrossRef]
- De Rosa, S.; De Giulio, A.; Iodice, C. Biological Effects of Prenylated Hydroquinones-Structure-Activity Relationship Studies in Antimicrobial, Brine Shrimp, and Fish Lethality Assays. J. Nat. Prod. 1994, 57, 1711–1716. [Google Scholar] [CrossRef]
- Bosio, C.; Tomasoni, G.; Martinez, R.; Olea, A.F.; Carrasco, H.; Villena, J. Cytotoxic and apoptotic effects of leptocarpin, a plant-derived sesquiterpene lactone, on human cancer cell lines. Chem. Biol. Interact. 2015, 242, 415–421. [Google Scholar] [CrossRef]
- Vengurlekar, S.; Sharma, R.; Trivedi, P. Efficacy of some natural compounds as antifungal agents. Pharm. Rev. 2012, 6, 91–99. [Google Scholar] [CrossRef] [Green Version]
- Espinoza, L.; Baeza, E.; Catalan, K.; Osorio, M.; Carrasco, H.; Cuellar, M.; Villena, J. Synthesis and Antitumor Activity of Diterpenylhydroquinone Derivatives of Natural Ent-Labdanes. Molecules 2010, 15, 6502–6511. [Google Scholar] [CrossRef]
- Baeza, E.; Catalan, K.; Villena, J.; Carrasco, H.; Cuellar, M.; Espinoza, L. Synthesis and cytotoxic activity of geranylmethoxyhydroquinone derivatives. J. Chil. Chem. Soc. 2012, 57, 1219–1223. [Google Scholar] [CrossRef] [Green Version]
- Carrasco, H.; Raimondi, M.; Svetaz, L.; Di Liberto, M.; Rodriguez, M.V.; Espinoza, L.; Madrid, A.; Zacchino, S. Antifungal activity of eugenol analogues. Influence of different substituents and studies on mechanism of action. Molecules 2012, 17, 1002–1024. [Google Scholar] [CrossRef] [PubMed] [Green Version]
- Espinoza, L.; Taborga, L.; Diaz, K.; Olea, A.F.; Peña-Cortes, H. Synthesis of linear geranylphenols and their effect on mycelial growth of plant pathogen Botrytis cinerea. Molecules 2014, 19, 1512–1526. [Google Scholar] [CrossRef] [Green Version]
- Taborga, L.; Diaz, K.; Olea, A.F.; Reyes-Bravo, P.; Flores, M.E.; Pena-Cortes, H.; Espinoza, L. Effect of Polymer Micelles on Antifungal Activity of Geranylorcinol Compounds against Botrytis cinerea. J. Agric. Food Chem. 2015, 63, 6890–6896. [Google Scholar] [CrossRef] [PubMed]
- Olea, A.F.; Bravo, A.; Martínez, R.; Thomas, M.; Sedan, C.; Espinoza, L.; Zambrano, E.; Carvajal, D.; Silva-Moreno, E.; Carrasco, H. Antifungal Activity of Eugenol Derivatives against Botrytis cinerea. Molecules 2019, 24, 1239. [Google Scholar] [CrossRef] [Green Version]
- Bakkali, F.; Averbeck, S.; Averbeck, D.; Idaomar, M. Biological effects of essential oils—A review. Food Chem. Toxicol. 2008, 46, 446–475. [Google Scholar] [CrossRef]
- Pandey, A.; Kumar, P.; Singh, P.; Tripathi, N.N.; Bajpai, V. Essential Oils: Sources of Antimicrobials and Food Preservatives. Front. Microbiol. 2017, 7, 2161. [Google Scholar] [CrossRef] [PubMed] [Green Version]
- Stratakos, A.C.; Koidis, A. Chapter 4—Methods for Extracting Essential Oils. In Essential Oils in Food Preservation, Flavor and Safety; Preedy, V.R., Ed.; Academic Press: San Diego, CA, USA, 2016; pp. 31–38. [Google Scholar]
- Lei, G.; Li, J.; Zheng, T.; Yao, J.; Chen, J.; Duan, L. Comparative Chemical Profiles of Essential Oils and Hydrolate Extracts from Fresh Flowers of Eight Paeonia suffruticosa Andr. Cultivars from Central China. Molecules 2018, 23, 3268. [Google Scholar] [CrossRef] [PubMed] [Green Version]
- Değirmenci, H.; Erkurt, H. Relationship between volatile components, antimicrobial and antioxidant properties of the essential oil, hydrosol and extracts of Citrus aurantium L. flowers. J. Infect. Public Health 2020, 13, 58–67. [Google Scholar] [CrossRef] [PubMed]
- Hamdi, A.; Majouli, K.; Vander Heyden, Y.; Flamini, G.; Marzouk, Z. Phytotoxic activities of essential oils and hydrosols of Haplophyllum tuberculatum. Ind. Crop. Prod. 2017, 97, 440–447. [Google Scholar] [CrossRef]
- Soylu, E.M.; Kurt, S.; Soylu, S. In vitro and in vivo antifungal activities of the essential oils of various plants against tomato grey mould disease agent Botrytis cinerea. Int. J. Food Microbiol. 2010, 143, 183–189. [Google Scholar] [CrossRef]
- Tripathi, P.; Dubey, N.K.; Shukla, A.K. Use of some essential oils as post-harvest botanical fungicides in the management of grey mould of grapes caused by Botrytis cinerea. World J. Microbiol. Biotechnol. 2008, 24, 39–46. [Google Scholar] [CrossRef]
- Zhang, J.; Ma, S.; Du, S.; Chen, S.; Sun, H. Antifungal activity of thymol and carvacrol against postharvest pathogens Botrytis cinerea. J. Food Sci. Technol. 2019, 56, 2611–2620. [Google Scholar] [CrossRef]
- Nazzaro, F.; Fratianni, F.; Coppola, R.; Feo, V. Essential Oils and Antifungal Activity. Pharmaceuticals 2017, 10, 86. [Google Scholar] [CrossRef] [Green Version]
- Stević, T.; Berić, T.; Šavikin, K.; Soković, M.; Gođevac, D.; Dimkić, I.; Stanković, S. Antifungal activity of selected essential oils against fungi isolated from medicinal plant. Ind. Crop. Prod. 2014, 55, 116–122. [Google Scholar] [CrossRef]
- D’Amato, S.; Serio, A.; López, C.C.; Paparella, A. Hydrosols: Biological activity and potential as antimicrobials for food applications. Food Control 2018, 86, 126–137. [Google Scholar] [CrossRef]
- Di Vito, M.; Smolka, A.; Proto, M.R.; Barbanti, L.; Gelmini, F.; Napoli, E.; Bellardi, M.G.; Mattarelli, P.; Beretta, G.; Sanguinetti, M.; et al. Is the Antimicrobial Activity of Hydrolates Lower than That of Essential Oils? Antibiotics 2021, 10, 88. [Google Scholar] [CrossRef]
- Tabet Zatla, A.; Dib, M.E.A.; Djabou, N.; Ilias, F.; Costa, J.; Muselli, A. Antifungal activities of essential oils and hydrosol extracts of Daucus carota subsp. sativus for the control of fungal pathogens, in particular gray rot of strawberry during storage. J. Essent. Oil Res. 2017, 29, 391–399. [Google Scholar] [CrossRef]
- Harris, R. Synergism in the essential oil world. Int. J. Aromather. 2002, 12, 179–186. [Google Scholar] [CrossRef]
- Gutierrez, J.; Barry-Ryan, C.; Bourke, P. Antimicrobial activity of plant essential oils using food model media: Efficacy, synergistic potential and interactions with food components. Food Microbiol. 2009, 26, 142–150. [Google Scholar] [CrossRef] [PubMed]
- Rosato, A.; Vitali, C.; Piarulli, M.; Mazzotta, M.; Argentieri, M.P.; Mallamaci, R. In vitro synergic efficacy of the combination of Nystatin with the essential oils of Origanum vulgare and Pelargonium graveolens against some Candida species. Phytomedicine 2009, 16, 972–975. [Google Scholar] [CrossRef] [PubMed]
- Bassolé, I.H.; Juliani, H.R. Essential oils in combination and their antimicrobial properties. Molecules 2012, 17, 3989–4006. [Google Scholar] [CrossRef] [Green Version]
- Ilić, B.S.; Kocić, B.D.; Ćirić, V.M.; Cvetković, O.G.; Miladinović, D.L. An In Vitro Synergistic Interaction of Combinations of Thymus glabrescens Essential Oil and Its Main Constituents with Chloramphenicol. Sci. World J. 2014, 2014, 826219. [Google Scholar] [CrossRef] [Green Version]
- Fu, Y.; Zu, Y.; Chen, L.; Shi, X.; Wang, Z.; Sun, S.; Efferth, T. Antimicrobial activity of clove and rosemary essential oils alone and in combination. Phytother. Res. 2007, 21, 989–994. [Google Scholar] [CrossRef] [PubMed]
- Nikkhah, M.; Hashemi, M.; Najafi, M.B.H.; Farhoosh, R. Synergistic effects of some essential oils against fungal spoilage on pear fruit. Int. J. Food Microbiol. 2017, 257, 285–294. [Google Scholar] [CrossRef]
- Elad, Y.; Gullino, M.L.; Shtienberg, D.; Aloi, C. Managing Botrytis cinerea on tomatoes in greenhouses in the Mediterranean. Crop Prot. 1995, 14, 105–109. [Google Scholar] [CrossRef]
- Wang, J.; Xia, X.-M.; Wang, H.-Y.; Li, P.-P.; Wang, K.-Y. Inhibitory effect of lactoferrin against gray mould on tomato plants caused by Botrytis cinerea and possible mechanisms of action. Int. J. Food Microbiol. 2013, 161, 151–157. [Google Scholar] [CrossRef]
- Romanazzi, G.; Droby, S. Control Strategies for Postharvest Grey Mould on Fruit Crops. In Botrytis—The Fungus, the Pathogen and Its Management in Agricultural Systems; Fillinger, S., Elad, Y., Eds.; Springer International Publishing: Cham, Switzerland, 2016; pp. 217–228. [Google Scholar]
- Zhang, C.-Y.; Guo, M. Comparing Three Different Extraction Techniques on Essential Oil Profiles of Cultivated and Wild Lotus (Nelumbo nucifera) Flower. Life 2020, 10, 209. [Google Scholar] [CrossRef]
- Bhaskara Reddy, M.V.; Angers, P.; Gosselin, A.; Arul, J. Characterization and use of essential oil from Thymus vulgaris against Botrytis cinerea and Rhizopus stolonifer in strawberry fruits. Phytochemistry 1998, 47, 1515–1520. [Google Scholar] [CrossRef]
- Bouchra, C.; Achouri, M.; Hassani, L.M.I.; Hmamouchi, M. Chemical composition and antifungal activity of essential oils of seven Moroccan Labiatae against Botrytis cinerea Pers: Fr. J. Ethnopharmacol. 2003, 89, 165–169. [Google Scholar] [CrossRef]
- Arras, G.; Usai, M. Fungitoxic activity of 12 essential oils against four postharvest citrus pathogens: Chemical analysis of thymus capitatus oil and its effect in subatmospheric pressure conditions. J. Food Prot. 2001, 64, 1025–1029. [Google Scholar] [CrossRef]
- Nieto, G. A Review on Applications and Uses of Thymus in the Food Industry. Plants 2020, 9, 961. [Google Scholar] [CrossRef]
- Marino, A.; Nostro, A.; Mandras, N.; Roana, J.; Ginestra, G.; Miceli, N.; Taviano, M.F.; Gelmini, F.; Beretta, G.; Tullio, V. Evaluation of antimicrobial activity of the hydrolate of Coridothymus capitatus (L.) Reichenb. fil. (Lamiaceae) alone and in combination with antimicrobial agents. BMC Complement Med. Ther. 2020, 20, 89. [Google Scholar] [CrossRef]
- Lee, S.O.; Choi, G.J.; Jang, K.S.; Lim, H.K.; Cho, K.Y.; Kim, J.C. Antifungal activity of five plant essential oils as fumigant against postharvest and soilborne plant pathogenic fungi. Plant Pathol. J. 2007, 23, 97–102. [Google Scholar] [CrossRef]
- Begnini, K.R.; Nedel, F.; Lund, R.G.; Carvalho, P.H.; Rodrigues, M.R.; Beira, F.T.; Del-Pino, F.A. Composition and antiproliferative effect of essential oil of Origanum vulgare against tumor cell lines. J. Med. Food 2014, 17, 1129–1133. [Google Scholar] [CrossRef]
- Balusamy, S.R.; Perumalsamy, H.; Huq, M.A.; Balasubramanian, B. Anti-proliferative activity of Origanum vulgare inhibited lipogenesis and induced mitochondrial mediated apoptosis in human stomach cancer cell lines. Biomed. Pharmacother. 2018, 108, 1835–1844. [Google Scholar] [CrossRef]
- Slaghenaufi, D.; Ugliano, M. Norisoprenoids, Sesquiterpenes and Terpenoids Content of Valpolicella Wines during Aging: Investigating Aroma Potential in Relationship to Evolution of Tobacco and Balsamic Aroma in Aged Wine. Front. Chem. 2018, 6, 66. [Google Scholar] [CrossRef] [Green Version]
- Šernaitė, L.; Rasiukevičiūtė, N.; Valiuškaitė, A. Application of Plant Extracts to Control Postharvest Gray Mold and Susceptibility of Apple Fruits to B. cinerea from Different Plant Hosts. Foods 2020, 9, 1430. [Google Scholar] [CrossRef]
- Townsend, G.R.; Heuberger, J.W. Methods for estimating losses caused by diseases in fungicides experiments. Plant Dis. Report. 1943, 27, 340–343. [Google Scholar]
- Ojeda-Contreras, A.-J.; Hernández-Martínez, J.; Domínguez, Z.; Mercado-Ruiz, J.-N.; Troncoso-Rojas, R.; Sánchez-Estrada, A.; Tiznado-Hernández, M.-E. Utilization of Caffeic Acid Phenethyl Ester to Control Alternaria alternata Rot in Tomato (Lycopersicon esculentum Mill.) Fruit. J. Phytopathol. 2008, 156, 164–173. [Google Scholar] [CrossRef]
Publisher’s Note: MDPI stays neutral with regard to jurisdictional claims in published maps and institutional affiliations. |
© 2021 by the authors. Licensee MDPI, Basel, Switzerland. This article is an open access article distributed under the terms and conditions of the Creative Commons Attribution (CC BY) license (https://creativecommons.org/licenses/by/4.0/).